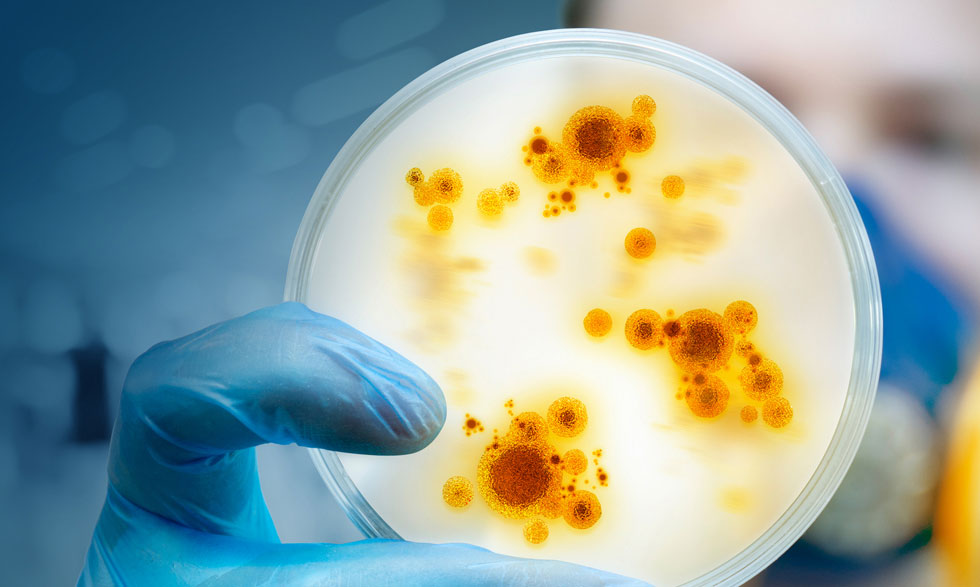
antibiotics wt18

Chemistry researchers from the University of Warwick, England, have accidentally discovered a highly potent new antibiotic. This medicine has the ability to kill seven different types of bacteria responsible for diseases such as skin, blood, and urinary infections.
This is considered a major breakthrough because the world is currently facing a growing problem known as Antimicrobial Resistance (AMR) — a condition where certain bacteria develop resistance against existing medicines, making infections harder to treat.
The Accidental Discovery
This new antibiotic was discovered accidentally during the process of producing another common antibiotic called Methylenomycin A. While Methylenomycin A works against most gram-negative bacteria, it is ineffective against drug-resistant strains.
During this research, scientists came across a chemical intermediate compound named Premethylenomycin C lactone, which turned out to be the new antibiotic. Surprisingly, this compound was found to be 100 times more powerful than Methylenomycin A in laboratory tests.
An Unexpected Outcome
Professor Gregory Challis, a chemistry expert from the University of Warwick, said: “People often assume that evolution perfects the final product, making it the best version. But in this case, it’s the intermediate compound—Premethylenomycin C lactone—that shows extraordinary potency.”
Challis and his research team isolated all the enzymes involved in the production of Methylenomycin A and studied them individually. During these tests, they found that the intermediate compound had strong antibacterial properties of its own.

Test Results
In experiments, scientists discovered that just 1 microgram of Premethylenomycin C lactone was enough to kill 1 millilitre of Staphylococcus aureus (S. aureus) a bacterium responsible for skin, blood, and internal infections. By comparison, it took 256 milligrams of Methylenomycin A to achieve the same effect.This clearly demonstrates how extremely potent the new compound is.
Naturally Occurring Antibiotics
The bacterium that produces this compound is called Streptomyces coelicolor A, commonly found in soil. Such bacteria naturally create antibiotics to defend themselves against fungi and rival microbes. Humans later extract and use these natural antibiotics for medical purposes.
As these bacteria produce antibiotics, they go through multiple chemical stages, forming new compounds at each step. The newly found Premethylenomycin C lactone is one of these intermediate compounds.
A Hidden Secret in an Old Medicine
Methylenomycin A was discovered 50 years ago, and though it has been synthesized several times since, none of its intermediate compounds were ever tested for antibacterial power—until now.
That’s what makes this new research so significant.
The findings were published on October 27 in the Journal of the American Chemical Society.

Why This Discovery Matters
According to a report published in Nature, Antimicrobial Resistance (AMR) could cause over 39 million deaths in the next 25 years. This means that as bacteria and viruses become more resistant to existing drugs, current antibiotics are losing effectiveness.
The World Health Organization (WHO) stresses that developing new and more powerful antibiotics is crucial to combat this growing threat. However, the WHO’s recent report (October 2) revealed that among 90 antibacterial drugs currently in development, only 15 are considered innovative — indicating a severe shortage of new treatments.
A Ray of Hope for the Future
In this context, the University of Warwick’s discovery shines as a ray of hope for global medical research. It could help fight drug-resistant bacteria and save countless lives. Scientists plan to take this study to the next stage of clinical research. If successful, it could mark the beginning of a new era in modern medicine, potentially revolutionizing the way we fight bacterial infections.












